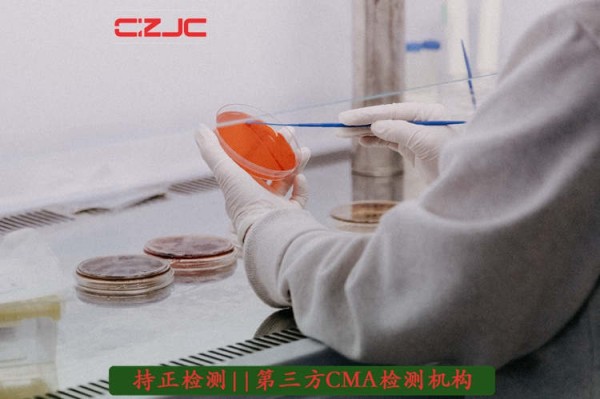
江西省一次性清洁用品检测--持正检测

江西省一次性清洁用品检测
购买一次性洗漱用品节省清洁时间 #生活技巧# #居家生活技巧# #懒人生活技巧# #懒人出行#
江西省一次性清洁用品检测--持正检测 通过参加*市场管理局组织的一次性口罩能力验证,评估实验室综合检测能力,进而提升一次性口罩的产品质量安全.方法:依据《一次性使用卫生用品中致病菌的检测参试指导书》及GB15979-2002《一次性使用卫生用品卫生标准》附录B的相关条款进行检测,在菌株分离上采用辅助检测方法:增加金黄色葡萄球菌,假单胞菌属显色培养基的划线,目的增加对目标菌的分离和准确鉴定.采用标准要求用传统生化鉴定方法对血平板,十六烷三甲基溴化铵琼脂培养基分离出来的可疑菌落进行生化鉴定,同时也对辅助检测方法显色平板分离出来的可疑菌落进行传统鉴定,对难判定的假单胞菌属显色培养基生长的可疑菌落再增加全自动生化鉴定仪进行生化鉴定.结果:传统方法鉴定结果与全自动生化鉴定仪鉴定的结果一致,*市场管理局于2020年及2022年共组织了2次一次性口罩能力验证实验,本实验室能力验证结果评价均为满意,实验室的检测能力获得认可.结论:本实验室一次性口罩能力验证的检测方法及质量控制策略是可行的,值得.

所有进口到的一次性使用卫生用品都必须符合以下要求,才能顺利通关: 1、报检方必须提供由具有CNAS资质的检测机构出具的相关检测报告;2、产品必须具有符合要求的中文标识;3、包装破损、卫生状况不良、过期、掺杂废旧产品等以次充好的一次性使用卫生用品,都将被实施退运或销毁处理。
一次性清洁用品检测 自2006年进口一次性使用卫生用品列入检验目录以来,*质检局一直将此类进口商品的检验监管作为重点工作来抓,*质检局于2005年末和2013年初,相继发布了《关于做好进口一次性使用卫生用品检验监管工作的通知》和《质检局关于进一步加强进口一次性使用卫生用品检验监管工作的通知》等文件,要求各级检验检疫机构对用于人体卫生的进口一次性使用卫生用品严格按照我国标准实施检验,不断提高进口一次性使用卫生用品检验监管工作的针对性、规范性、有效性,保障进口一次性使用卫生用品质量安全,维护我国消费者的身体健康和权益。
无法符合相关要求的产品将被退运或作销毁处理。根据2013年进口- -次性使用卫生用品质量状况中的数据,该年检验的进口- -次性使用卫生用品不合格率为8.6% ,重不合格率为8.78% ,货值不合格率为11.8%。不合格原因主要为:微生物标、产品包装不合格、产品品质不合格以及未提供毒理检测报告。提醒欲将此类产品进口的企业:在产品装运前获得符合要求的检测报告不仅能够加速产品清关,还能够避免由于产品不合规无法入关带来的巨大经济损失。

一次性清洁用品检测 由于一次性卫生用品可以直接与皮肤接触,其质量的好坏直接能够影响使用者的身体健康。近年来,一次性卫生用品抽检微生物标的案例也时有发生,一次性卫生用品检测刻不容缓。持正检测取得CMA资质,能够提供一次性卫生用品检测,出具具有公信力的检测报告。

近年来,随着国内居民生活水平的提高,对于一次性使用卫生用品的需求也出现大幅增长,特别是儿童消费热持续升温和老龄人口不断增加,以儿童纸尿裤、成人尿布等产品为代表的进口一次性使用卫生用品出现持续快速增长。
持正检测公司可提供如下个方面的检测能力(dsfzpz2211):1、洁净室(区)及相关受控环境;2、生物安全实验室;3、实验动物环境及设施;4、医院受控环境(手术室、辅助用房、ICU病房等);5、电子信息系统机房环境;6、生产环境卫生指标;7、物料储存环境(仓库);8、设备、管道空气过滤系统已安装过滤器完整性;9、洁净工作台(包括层流罩、采样车、隔离器等局部净化设备/装置);10、生物安全柜
网址:江西省一次性清洁用品检测 https://www.yuejiaxmz.com/news/view/1451424
相关内容
陕西省一次性清洁用品检测检测公司外卖行业一次性清洁用品检测检测第三方公司
一次性清洁巾检测报告在哪可以办理?—企检网
「一次性清洁用品」一次性清洁用品公司黄页
「一次性卫生用品※」一次性卫生用品※公司黄页
「一次性清洁」一次性清洁公司黄页
一次性清洁怎么样
家居清洁,洗浴用品,一次性用品
西门子空气检测仪新品发布 守护每一次呼吸
适度使用一次性清洁用品

